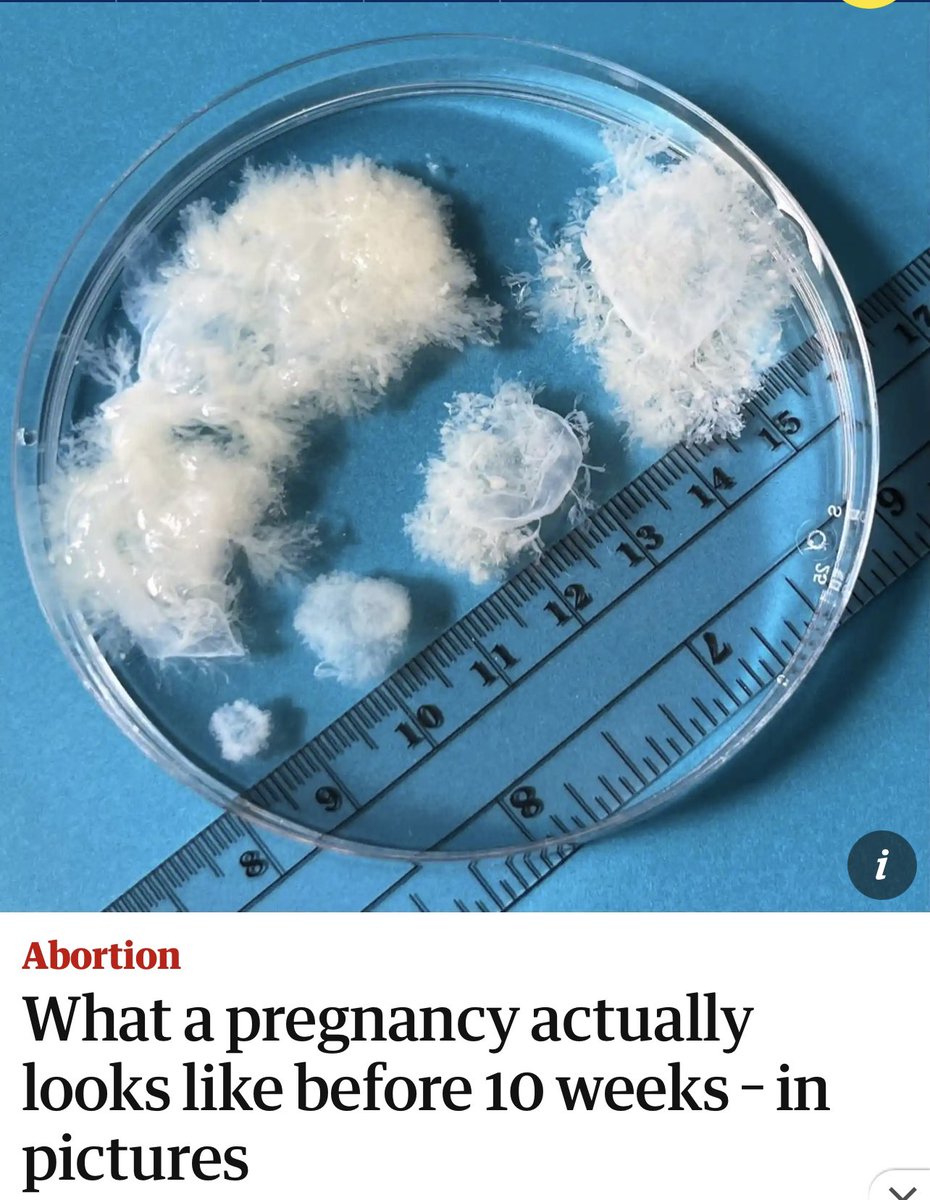
To top it off, Judge Kacsmaryk rejects the term "fetus" &amp; uses "unborn human" or "unborn child" instead. 

He’s literally ruling from the bench based on his religious beliefs. 

Whatever you do, don’t RT this picture of what a pregnancy looks like at 10 weeks.

Don’t do it.

Heather C
@heather_cas
ID: 28897124
04-04-2009 23:48:00
4,4K Tweet
97 Followers
96 Following

#McFlyTotalAccess What does EPCOT stand for? Experimental Prototype Community of Tomorrow. Danny Jones mcfly Harry Judd Dougie Poynter Tom Fletcher

#McFlyTotalAccess can’t wait to watched the boys watch this!! Danny Jones Dougie Poynter Harry Judd Tom Fletcher


#McFlyTotalAccess I vaguely remember someone saying Giovanna Fletcher played cow bell in Everybody Knows. Am I remembering this correctly? Danny Jones Harry Judd Dougie Poynter Tom Fletcher

I dying at this rewatch 😂😂 #McFlyTotalAccess Danny Jones Harry Judd Dougie Poynter Tom Fletcher

#McFlyTotalAccess don’t be sorry, it’s a great source of laughter 😂😂 Danny Jones Harry Judd Dougie Poynter Tom Fletcher

Hit that G Tom Fletcher







Best fucking day of my life! I can’t believe I got to go into mcfly studio and meet them! Definitely a dream come true! Tom Fletcher Danny Jones Dougie Poynter Harry Judd


The new episodes of #LegendOfVoxMachina are so amazing and I cried so much! Loved them so much! The animation was so beautiful! Critical Role Laura Bailey Sam Riegel Liam O'Brien Matthew Mercer Travis Willingham Taliesin Jaffe Titmouse Animation Marisha Ray


My new babies Artagan McFly and Jester Lavorre ❤️ Critical Role Laura Bailey Matthew Mercer Sam Riegel Liam O'Brien Travis Willingham mcfly


I had a dream last night that I met Mark Hamill and I was adamant that I tell him I love how he signs his name on here (mar🐫) and how my dad would have also loved it. 😂